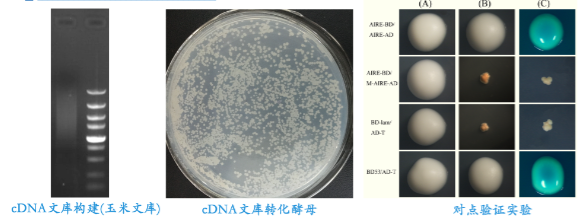

酵母单杂交
技术简介
酵母单杂交(Yeast one-hybrid)是根据DNA结合蛋白(即转录因子)与DNA顺式作用元件结合调控报道基因表达的原理,克隆与靶元件特异结合的转录因子基因(cDNA)的有效方法。其理论基础是:许多真核生物的转录激活子由物理和功能上独立的DNA结合区(DNA-binding domain BD)和转录激活区(Activation domain AD)组成,因此可构建各种基因与AD的融合表达载体,在酵母中表达为融合蛋白时,根据报道基因的表达情况,便能筛选出与靶元件有特异结合区域的蛋白。理论上,在单杂交检测中,任何靶元件都可被用于筛选一种与之有特异结合区域的蛋白。
应用酵母单杂交体系已经验证了许多已知的DNA与蛋白质之间的相互作用,同时发现了新的DNA与蛋白质的相互作用,并由此找到了多种新的转录因子。

酵母单杂交(上)与酵母双杂交(下)原理图
应用领域
酵母单杂交方法检测特定转录因子与顺式作用元件专一性相互作用的敏感性和可靠性,现已被广泛用于克隆细胞中含量微弱的、用生化手段难以纯化的特定转录因子。
目前,在研究DNA—蛋白质相互作用中,酵母单杂交体系主要有以下3种用途:
①确定已知DNA—蛋白质之间是否存在相互作用;
②分离结合于目的顺式调控元件或其他短DNA结合位点蛋白的新基因;
③定位已经证实的具有相互作用的DNA结合蛋白的DNA结合结构域,以及准确定位与DNA结合的核苷酸序列。
服务内容
| 项目分类 | 服务内容 |
| 酵母单杂交文库构建 | 双链cDNA转化AH109酵母感受态细胞,收集转化子及检测文库质量 |
| 诱饵载体的构建 | 将目的基因构建至PGBKT7 |
| 酵母单杂交筛选及鉴定 | 诱饵质粒转酵母感受态细胞,经验证后,再将文库质粒转入含有诱饵质粒的酵母感受态中,筛选分析互作结果 |
技术优势
1. 专业的技术团队使您的实验高效、准确;
2. 丰富的分子实验基础,尤其在酵母杂交中积累了大量的实践经验,有成熟的实验技术,满足客户不同的实验需求
服务流程(图)
酵母单杂交文库构建——诱饵载体构建——诱饵载体自激活检测——诱饵质粒转化酵母感受态细胞及验证—文库质粒转化酵母感受态细胞——文库筛选、分析

您需要提供以下材料
1. 新鲜组织材料、冻存材料或高质量RNA、诱饵基因的模板
2. 尽可能全面的实验相关信息
您将获得以下结果
1. 构建好的单杂交文库甘油菌:文库容量≥106;文库滴度>107cfu/ml;插入片段平均大于500bp(不同物种略有差别);减低高丰度表达基因10-100倍;2. 酵母单杂交筛选得到的阳性克隆;
3. 实验过程报告及相关数据图片。
实验结果图片示例: